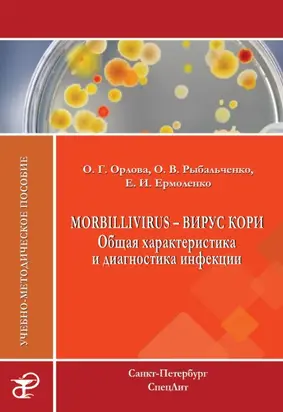
Morbillivirus – вирус кори. Общая характеристика и диагностика инфекции. Учебно-методическое пособие

Knowing Your Horse
Is your horse afraid of the farrier? Are you both struggling during training sessions? Do you want to use clicker training but don’t know where to begin? If you understand how your horse learns and why your training is effective, you can train faster, more ethically, and more sympathetically. Knowing Your Horse will be a key resource if you want to better understand your horse’s behaviour and make the most of that understanding to improve your training techniques. Knowing Your Horse gives you a range of practical tools to employ in solving equine behaviour problems, and training tasks and case studies demonstrate these tools in use. Emma Lethbridge thoroughly but simply explains learning theory as applied to horses, and offers practical advice on reward systems, positive and negative reinforcement, and overcoming fears and phobias. If it’s not horses but humans that are causing you problems in training, this book will also help you to explain the concepts to other people. Learning recaps offer quick summaries and training logs are provided for your own training notes.
Скачать бесплатно книгу “Knowing Your Horse”
Доступные форматы для скачивания:
Комментарии 0